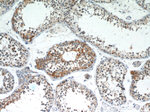
CSDE1 Antibody in Immunohistochemistry (Paraffin) (IHC (P))

Search
Proteintech
CSDE1 Polyclonal Antibody
{{$productOrderCtrl.translations['antibody.pdp.commerceCard.promotion.promotions']}}
{{$productOrderCtrl.translations['antibody.pdp.commerceCard.promotion.viewpromo']}}
{{$productOrderCtrl.translations['antibody.pdp.commerceCard.promotion.promocode']}}: {{promo.promoCode}} {{promo.promoTitle}} {{promo.promoDescription}}. {{$productOrderCtrl.translations['antibody.pdp.commerceCard.promotion.learnmore']}}
产品信息
13319-1-AP
种属反应
已发表种属
宿主/亚型
分类
类型
抗原
偶联物
形式
浓度
规格
纯化类型
保存液
内含物
保存条件
运输条件
产品详细信息
Immunogen sequence: EKEAEDGII AYDDCGVKLT IAFQAKDVEG STSPQIGDKV EFSISDKQRP GQQVATCVRL LGRNSNSKRL LGYVATLKDN FGFIETANHD KEIFFHYSEF SGDVDSLELG DMVEYSLSKG KGNKVSAEKV NKTHSVNGIT EEADPTIYSG KVIRPLRSVD PTQTEYQGMI EIVEEGDMKG EVYPFGIVGM ANKGDCLQKG ESVKFQLCVL GQNAQTMAYN ITPLRRATVE CVKDQFGFIN YEVGDSKKLF FHVKEVQDGI ELQAGDEVEF SVILNQRTGK CSACNVWRVC EGPKAVAAPR PDRLVNRLKN ITLDDASAPR LMVLRQPRGP DNSMGFGAER KIRQAGVID (440-798 aa encoded by BC032446)
靶标信息
CSDE1 gene ontology annotations related to this gene include regulation of transcription, DNA-templated.
仅用于科研。不用于诊断过程。未经明确授权不得转售。
生物信息学
蛋白别名: cold shock domain containing E1, RNA binding; Cold shock domain-containing protein E1; N-ras upstream gene protein; NRAS-related; Protein UNR; RP5-1000E10.3; unnamed protein product; upstream of NRAS
基因别名: AA960392; BC016898; CSDE1; D1S155E; D3Jfr1; KIAA0885; mKIAA0885; NRU; UNR
UniProt ID: (Human) O75534, (Mouse) Q91W50
Entrez Gene ID: (Human) 7812, (Mouse) 229663